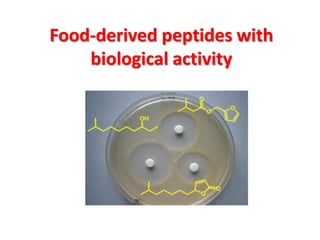
Food-derived peptides with
biological activity

Peptides are short chains of amino acids linked by peptide bonds. They are distinguished from proteins by typically containing fewer than 50 amino acid units. Peptides are formed through condensation reactions between carboxyl and amino groups of separate amino acids, releasing a water molecule. Peptide bonds are rigid and planar, contributing to protein structure stability. Peptides serve many important biological functions and can be classified based on their production method, including through ribosomal translation, nonribosomal synthesis, and enzymatic digestion of proteins in foods. Bioactive peptides derived from food proteins can have beneficial effects like lowering blood pressure, cholesterol, and antimicrobial properties.